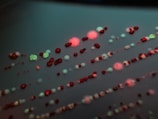
Close-up of a heat-loving microbe colony glowing in a deep-sea hydrothermal vent.
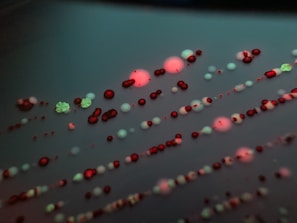
Close-up of a heat-loving microbe colony glowing in a deep-sea hydrothermal vent.

Life on Earth
Exploring microbes thriving in extreme places and their slow, steady dance through time.
Life on Earth Insights
Sharing stories of microbes thriving in extremes and the slow dance of life’s earliest forms.


150+
15
Trusted Voices
Readers
Microbial Wonders
Snapshots of life thriving in Earth's extremes.

Stay Connected
Join the journey through microbial mysteries